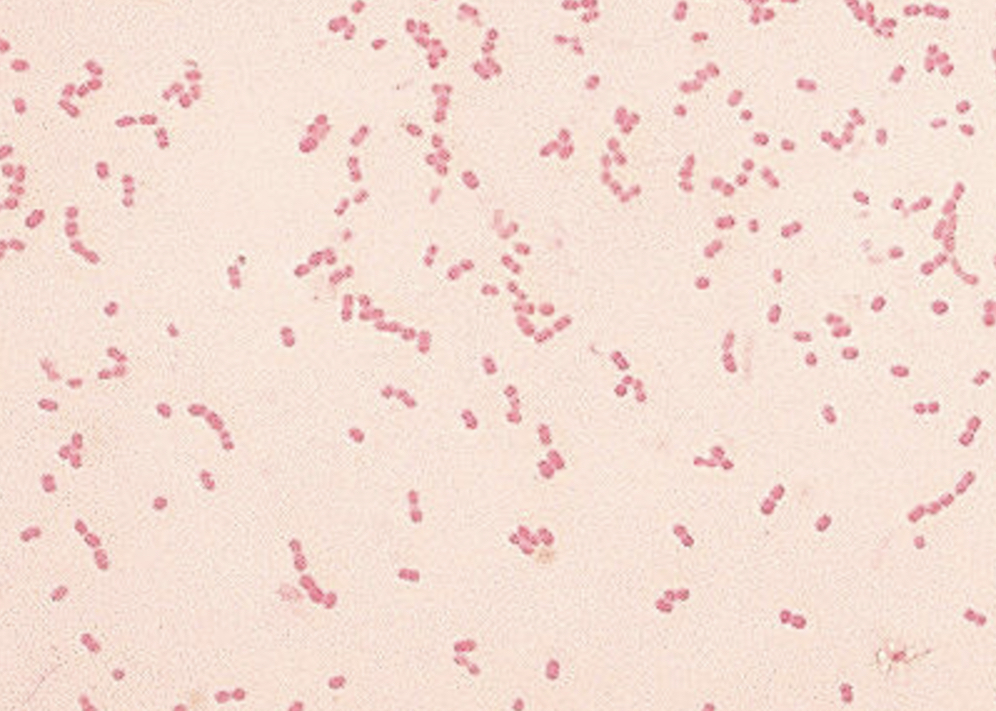
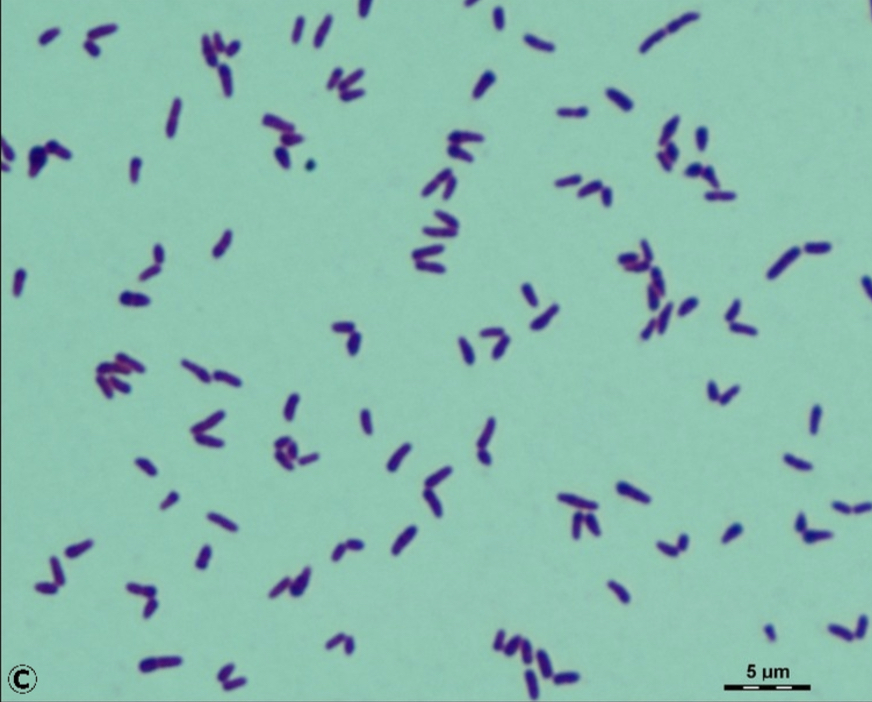

Bacterial morphology:
Spherical shaped and can appear singular or in pairs, chains, or clusters
Cocci
Bacterial morphology:
Rod shaped and can appear singular or in chains
bacillus
pl. bacilli
AKA rods
Bacterial morphology:
very short rods
coccobacilli
Bacterial morphology:
very long rods
Filamentous
Bacterial morphology:
tapered, pointed ends
Fusiform bacilli
Bacterial morphology:
Multiple shapes. The same organism may exhibit short rods, very long rods, or a variety of other shapes
Pleomorphic rods
Bacterial morphology:
helical shaped
Spirochetes
What are the reagents used in a gram stain?
If a organism stains purple/blue with the Gram stain, it is considered:
Positive
or
Negative
Positive
If a organism stains pink/red with the Gram stain, it is considered:
Positive
or
Negative
Negative
Identify the morphology:

Diplococci
Identify the morphology:

Bacilli
(streptobacilli)
Identify the morphology:
Coccobacilli
Identify the morphology:

Filamentous rod
Identify the morphology:

Fusiform rods
Identify the morphology:
Bacilli
(paslisade)
Identify the morphology:

Spirochete
What part of the bacterial structure causes the bacteria to keep the purple/blue color?
Peptidoglycan layer
-A thick peptidoglycan layer makes it more difficult to decolorize all of the crystal violet/iodine complex
During a gram stain, the decolorizer dissolves which part of the bacterial structure on gram negative microorganisms removing the crystal violet-iodine complex?
Phospholipid layer
Why do we heat fix smear?
(3)
How long is Crystal violet left on the slide?
30-60 seconds
How long is iodine left on the gram stain slide?
30-60 seconds
What is the most important step in the Gram stain process? Why?
Decolorization
-Smears can be over- or under-decolorized
How long is safranin left on the slide?
30-60 seconds